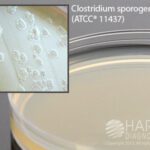
Egg Yolk Agar, Modified, Hardy Diagnostics - G215, Pack of 10, Egg Yolk Agar, Mod.

Blank Paper Disk for AST, Hardy Diagnostics - Z7121, 0.25 IN., Blank Disk
$16.97 Commercial Only
Egg Yolk Agar, Modified, Hardy Diagnostics - G215, Pack of 10, Egg Yolk Agar, Mod.
$102.40 Commercial Only
Vancomycin Disks, Hardy Diagnostics – Z7501, 50 disks, Vancomycin Disks
SKU:
ASR-Z7501-EA
Restricted Status
VANCOMYCIN VA-5 5 MCG F/DIFF ANARB BACT
$22.20 Commercial Only
Shipping
Authorities in our business will tell in no uncertain terms that Lorem Ipsum is that huge, huge no no to forswear forever. Not so fast, I'd say, there are some redeeming factors in favor of greeking text, as its use is merely the symptom of a worse problem to take into consideration.
Product details
VANCOMYCIN VA-5 5 MCG F/DIFF ANARB BACT
| Brand | HARDY DIAGNOSTICS |
|---|---|
| Manufacturer | HARDY DIAGNOSTICS |
| Product Size | 50 items |
| Size / Quantity | 1-EA |
Description
Size quantity : 1-EA
Description : Vancomycin, 5mcg, Va-5, for the differentiation of anaerobic bacteria based on susceptibility to vancomycin, 1 x 50 disks, for the identification of anaerobes, use with dispenser.
Related Products
Commercial Only
$172.02 Commercial Only
Commercial Only
$186.12 Commercial Only
Commercial Only
$634.05 Commercial Only
Commercial Only
$33.14 Commercial Only
Commercial Only
$80.46 Commercial Only
Commercial Only
$97.75 Commercial Only
Commercial Only
$125.62 Commercial Only
Commercial Only
$324.19 Commercial Only
Commercial Only
$68.77 Commercial Only
Commercial Only
$56.69 Commercial Only





